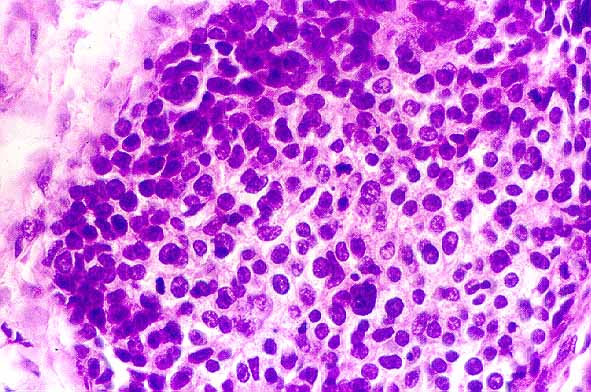
fig. 4

ComunicaciÛn
N∫ 010
ComunicaciÛn |
*LESPI, Pablo Javier, +DRUT, Ricardo
 |
| Figura 1. Nidos de cÈlulas basaloides que muestran depÛsitos intercelulares de material de tipo membrana basal. Se aprecia ademas carcinoma in situ en superficie (H E, x 40). |
 |
| Figura 2. Nidos de cÈlulas basaloides con empalizada perifÈrica y necrosis de tipo comedocarcinoma (H E, x 40). |
 |
| Figura 3. Material eosinofilo tipo membrana basal (H E, x 40). |
|
| Figura 4. CÈlulas con n˙cleos hipercrom·ticos, leve pleomorfismo y presencia de numerosas figuras mitÛticas (H E, x 400). |